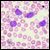

It is time to move on to next key steps of improving recognition of treatment-resistant lymphoma at diagnosis, rather than at treatment failure, by optimally employing biomarkers and improving cure rates by integrating powerful but minimally toxic new systemic agents into primary treatment.